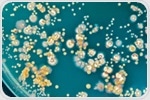
Scientists reveal global catalog of microbial small proteins, unlocking microbiome secrets

| Microbiology - Industrial Microbiology: An Overview |
|
|
|
|
| |

|
|
| |
The latest microbiology news from AZoNetwork |
|
|
|
 | | |
 Understanding Field Certifications of Biosafety Cabinets Understanding Field Certifications of Biosafety Cabinets
This expert guide delves into the critical process of biosafety cabinet (BSC) field certification. As essential engineering controls in laboratories, BSCs protect personnel, products, and the environment from biohazardous materials; understanding their certification process is necessary for maintaining lab safety.
| |
|
|
| |  | | | Researchers developed a global catalog of nearly one billion small open reading frames (smORFs) from microbial genomes, revealing significant protein diversity, particularly in archaea, and providing new tools for microbiome research. Researchers developed a global catalog of nearly one billion small open reading frames (smORFs) from microbial genomes, revealing significant protein diversity, particularly in archaea, and providing new tools for microbiome research. | | | | |  Study identifies phenylacetylglutamine (PAGln), a gut microbiome metabolite, as a novel allosteric modulator of β2-adrenergic receptors, offering insights into its role in cardiovascular disease (CVD) risk. Study identifies phenylacetylglutamine (PAGln), a gut microbiome metabolite, as a novel allosteric modulator of β2-adrenergic receptors, offering insights into its role in cardiovascular disease (CVD) risk. | | | | |  This week, the National Science Foundation announced the award of a six-year, $22M grant to UC Santa Barbara under its biofoundries program for the establishment of the BioFoundry for Extreme and Exceptional Fungi, Archaea and Bacteria (ExFAB), a collaboration led by UC Santa Barbara (UCSB), together with UC Riverside (UCR), and Cal Poly Pomona (CPP). This week, the National Science Foundation announced the award of a six-year, $22M grant to UC Santa Barbara under its biofoundries program for the establishment of the BioFoundry for Extreme and Exceptional Fungi, Archaea and Bacteria (ExFAB), a collaboration led by UC Santa Barbara (UCSB), together with UC Riverside (UCR), and Cal Poly Pomona (CPP). | | | | |  The surprising discovery of a bacterium in a marine sponge from the Great Barrier Reef with striking similarity to Mycobacterium tuberculosis, the pathogen responsible for tuberculosis (TB), could unlock and inform future TB research and treatment strategies. The surprising discovery of a bacterium in a marine sponge from the Great Barrier Reef with striking similarity to Mycobacterium tuberculosis, the pathogen responsible for tuberculosis (TB), could unlock and inform future TB research and treatment strategies. | |
|
|
| |  | | | How would you rate today's newsletter?
| |
|
|
|  | | |
 |
Stay updated with the latest in health and medical news! Follow News‑Medical.net on Google News for real‑time updates. Click here to follow us now. |
| |
|
|
|
|
|
|
|